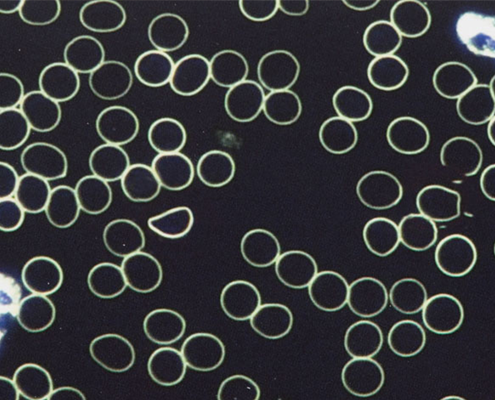
DUNKELFELDMIKROSKOPIE

Alle Therapien & Behandlungen
Wählen Sie Ihr Beschwerdebild oder die gewünschte Therapie aus unserem umfangreichen Angebot.

Was ist Alopecia areata (kreisrunder Haarausfall)?
Alopecia areata ist eine entzündliche Autoimmunerkrankung, bei der das körpereigene Immunsystem fälschlicherweise die...
Behandlung ansehen
BANDSCHEIBENVORFALL (DISKUSHERNIE)
Ein Bandscheibenvorfall – auch Diskushernie genannt – ist eine häufige Erkrankung der Wirbelsäule. Dabei tritt das we...
Behandlung ansehen
SCHUPPENFLECHTE (PSORIASIS VULGARIS)
Psoriasis vulgaris, auch bekannt als Schuppenflechte, ist eine chronische Hauterkrankung, die durch eine Überaktivitä...
Behandlung ansehen
DARMERKRANKUNGEN
Darmerkrankungen umfassen eine Vielzahl von Störungen, die den Dünn- oder Dickdarm betreffen. Dazu zählen chronische ...
Behandlung ansehen
KOPFSCHMERZEN NATÜRLICH LINDERN
Kopfschmerzen sind ein häufiges Symptom, das sich durch Schmerzen oder Druckgefühle im Kopf- oder Nackenbereich äußer...
Behandlung ansehen
DUNKELFELDMIKROSKOPIE
Die Dunkelfeldmikroskopie ist ein spezielles mikroskopisches Verfahren, bei dem lebendes Blut direkt nach der Abnahme...
Behandlung ansehen
MEDIZINISCHE MASSAGE
Die medizinische Massage ist eine therapeutische Form der Massage, die gezielt zur Behandlung von Beschwerden und Erk...
Behandlung ansehen
ULTRASCHALL (SONOGRAPHIE)
Die Sonographie, auch bekannt als Ultraschalluntersuchung, ist ein modernes, bildgebendes Verfahren, das mit hochfreq...
Behandlung ansehen
SPINNENADERN (VARIZEN)
Spinnenadern, auch bekannt als Varizen oder Besenreiser, sind erweiterte, oberflächliche Blutgefäße, die meist an den...
Behandlung ansehen
Akute Nierenerkrankungen
Ärzte bezeichnen das akute Nierenversagen oft als Akute Nierenerkrankung; es ist die Erkrankung, deren Auftreten zu…
Behandlung ansehen
SCHRÖPFEN
Schröpfen ist eine jahrtausendealte Therapieform aus der Naturheilkunde, bei der spezielle Schröpfgläser auf bestimmt...
Behandlung ansehen
DIABETES TYP 2
Diabetes Typ 2 ist eine chronische Stoffwechselerkrankung, bei der der Körper entweder zu wenig Insulin produziert od...
Behandlung ansehen
OHRENSCHMALZ SANFT ENTFERNEN
Ohrenschmalz (medizinisch: Cerumen) ist eine natürliche Substanz, die von den Drüsen im äußeren Gehörgang produziert ...
Behandlung ansehen
NAGELPILZ NATÜRLICH BEHANDELN
Nagelpilz (Onychomykose) ist eine häufige Infektion der Finger- oder Zehennägel, die durch Pilze wie Dermatophyten, H...
Behandlung ansehen
GANZHEITLICHE ERNÄHRUNGSBERATUNG IN DER NATURMEDIZIN
Die Ernährungsberatung im naturheilkundlichen Kontext verfolgt einen ganzheitlichen Ansatz. Ziel ist es, durch indivi...
Behandlung ansehen
PHYTOTHERAPIE
Die Phytotherapie – auch bekannt als pflanzliche Naturheilkunde – ist eine der ältesten Heilmethoden der Menschheit. ...
Behandlung ansehen
MANUELLE LYMPHDRAINAGE
Die manuelle Lymphdrainage ist eine sanfte massageähnliche Technik, die das Lymphsystem aktiviert, Wassereinlagerunge...
Behandlung ansehen
AUSLEITENDE VERFAHREN
Ausleitende Verfahren gehören zu den ältesten Therapieformen der Naturheilkunde. Ziel ist es, den Körper von überschü...
Behandlung ansehen
HAUTERKRANKUNGEN NATÜRLICH BEHANDELN
Hauterkrankungen, medizinisch auch Dermatosen genannt, umfassen eine Vielzahl von Beschwerden, die die Haut als größt...
Behandlung ansehen
DYSMENORRHÖ
Behandlung dauert 1 Tag vor der Menstruation oder 1-3 Tage nach der Menstruation!!!
Behandlung ansehen
SEHSCHWÄCHE NATÜRLICH BEHEBEN
Alle Altersklassen können gleichermassen von Augenkrankheiten oder einer Sehschwäche betroffen sein.
Behandlung ansehen
AKUTE NIERENINSUFFIZIENZ
Die akute Niereninsuffizienz (akutes Nierenversagen) beschreibt eine plötzliche, starke Einschränkung der Nierenfunkt...
Behandlung ansehen
CHRONISCHE NIERENERKRANKUNG
Die chronische Nierenerkrankung (CKD) beschreibt einen langsam fortschreitenden Funktionsverlust der Nieren über Mona...
Behandlung ansehen
POLYZYSTISCHE NIERENERKRANKUNG
Die polyzystische Nierenerkrankung (PKD) ist eine erblich bedingte, chronisch fortschreitende Erkrankung, bei der sic...
Behandlung ansehen
NEPHROTISCHES SYNDROM
Das nephrotische Syndrom ist ein Symptomkomplex verschiedener Nierenerkrankungen, bei dem die Filterfunktion der Nier...
Behandlung ansehen
KREATININ
Kreatinin ist ein Abbauprodukt des Muskelstoffwechsels und entsteht beim Zerfall von Kreatin, einem wichtigen Energie...
Behandlung ansehen
PROTEINURIE
Proteinurie bezeichnet das vermehrte Ausscheiden von Eiweissen (Proteinen) im Urin – ein Anzeichen dafür, dass die Fi...
Behandlung ansehen
Spinnenadern (Varizen)
Spinnenadern sind feine, erweiterte Blutgefässe, die meist an den Beinen auftreten und als dünne, rote oder blaue Lin...
Behandlung ansehen

Merkmale eines schönen Gesichts
Was macht eigentlich ein schönes Gesicht aus? Worin unterscheiden sich attraktive Gesichter von weniger attraktiven? ...
Behandlung ansehen
Hautpflege
Die Haut ist das grösste Organ des menschlichen Körpers und sollte demnach eine wichtige Rolle bei der Körperpflege e...
Behandlung ansehen
Po-Vergrösserung – mit Vakuum-Therapie
Ein zu flacher oder zu kleiner Po kann mit Hilfe von Vakuumtherapie auf sanfte Weise eine schönere Form erhalten.
Behandlung ansehen
NIE WIEDER DIE BEINE RASIEREN
Die klassischen Haarentfernungsmethoden, wie rasieren, Wachsen oder Zupfen, werden immer noch von vielen Männern und ...
Behandlung ansehen
Anti-Cellulite-Holztherapie
Die Anti-Cellulite-Holztherapie entfernt Fettansammlungen aus verschiedenen Körperteilen wie Hüften, Rücken oder Bauc...
Behandlung ansehen